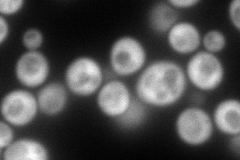
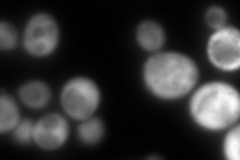
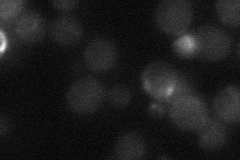

View description
Member of a stationary phase-induced gene family; transcription of SNZ2 is induced prior to diauxic shift, and also in the absence of thiamin in a Thi2p-dependent manner; forms a coregulated gene pair with SNO3
Localization:
Intensity:
Fold change:
Significance:
-
C’ GFP library in SD

below threshold13.54 -
N' NOP1pr-GFP in SD
cytosol227.847 -
N' TEF2pr-mCherry in SD
cytosol5.64141 -
N' NATIVEpr-GFP in SD
below threshold17.5906 -
N' TEF2pr-VC and Cyto-VN in SD

cytosol60.4982 -
C’ GFP library in SD+DTT

cytosolN/AN/ANo -
C’ GFP library in SD+H2O2

cytosol16.31.2No -
C’ GFP library in Starvation Media

technical problem0N/AYes -
C’ GFP library on the background of Pup2-DaMP

below threshold -
C’ GFP library on the background of CCT mutant

below threshold15.78461.16521No
